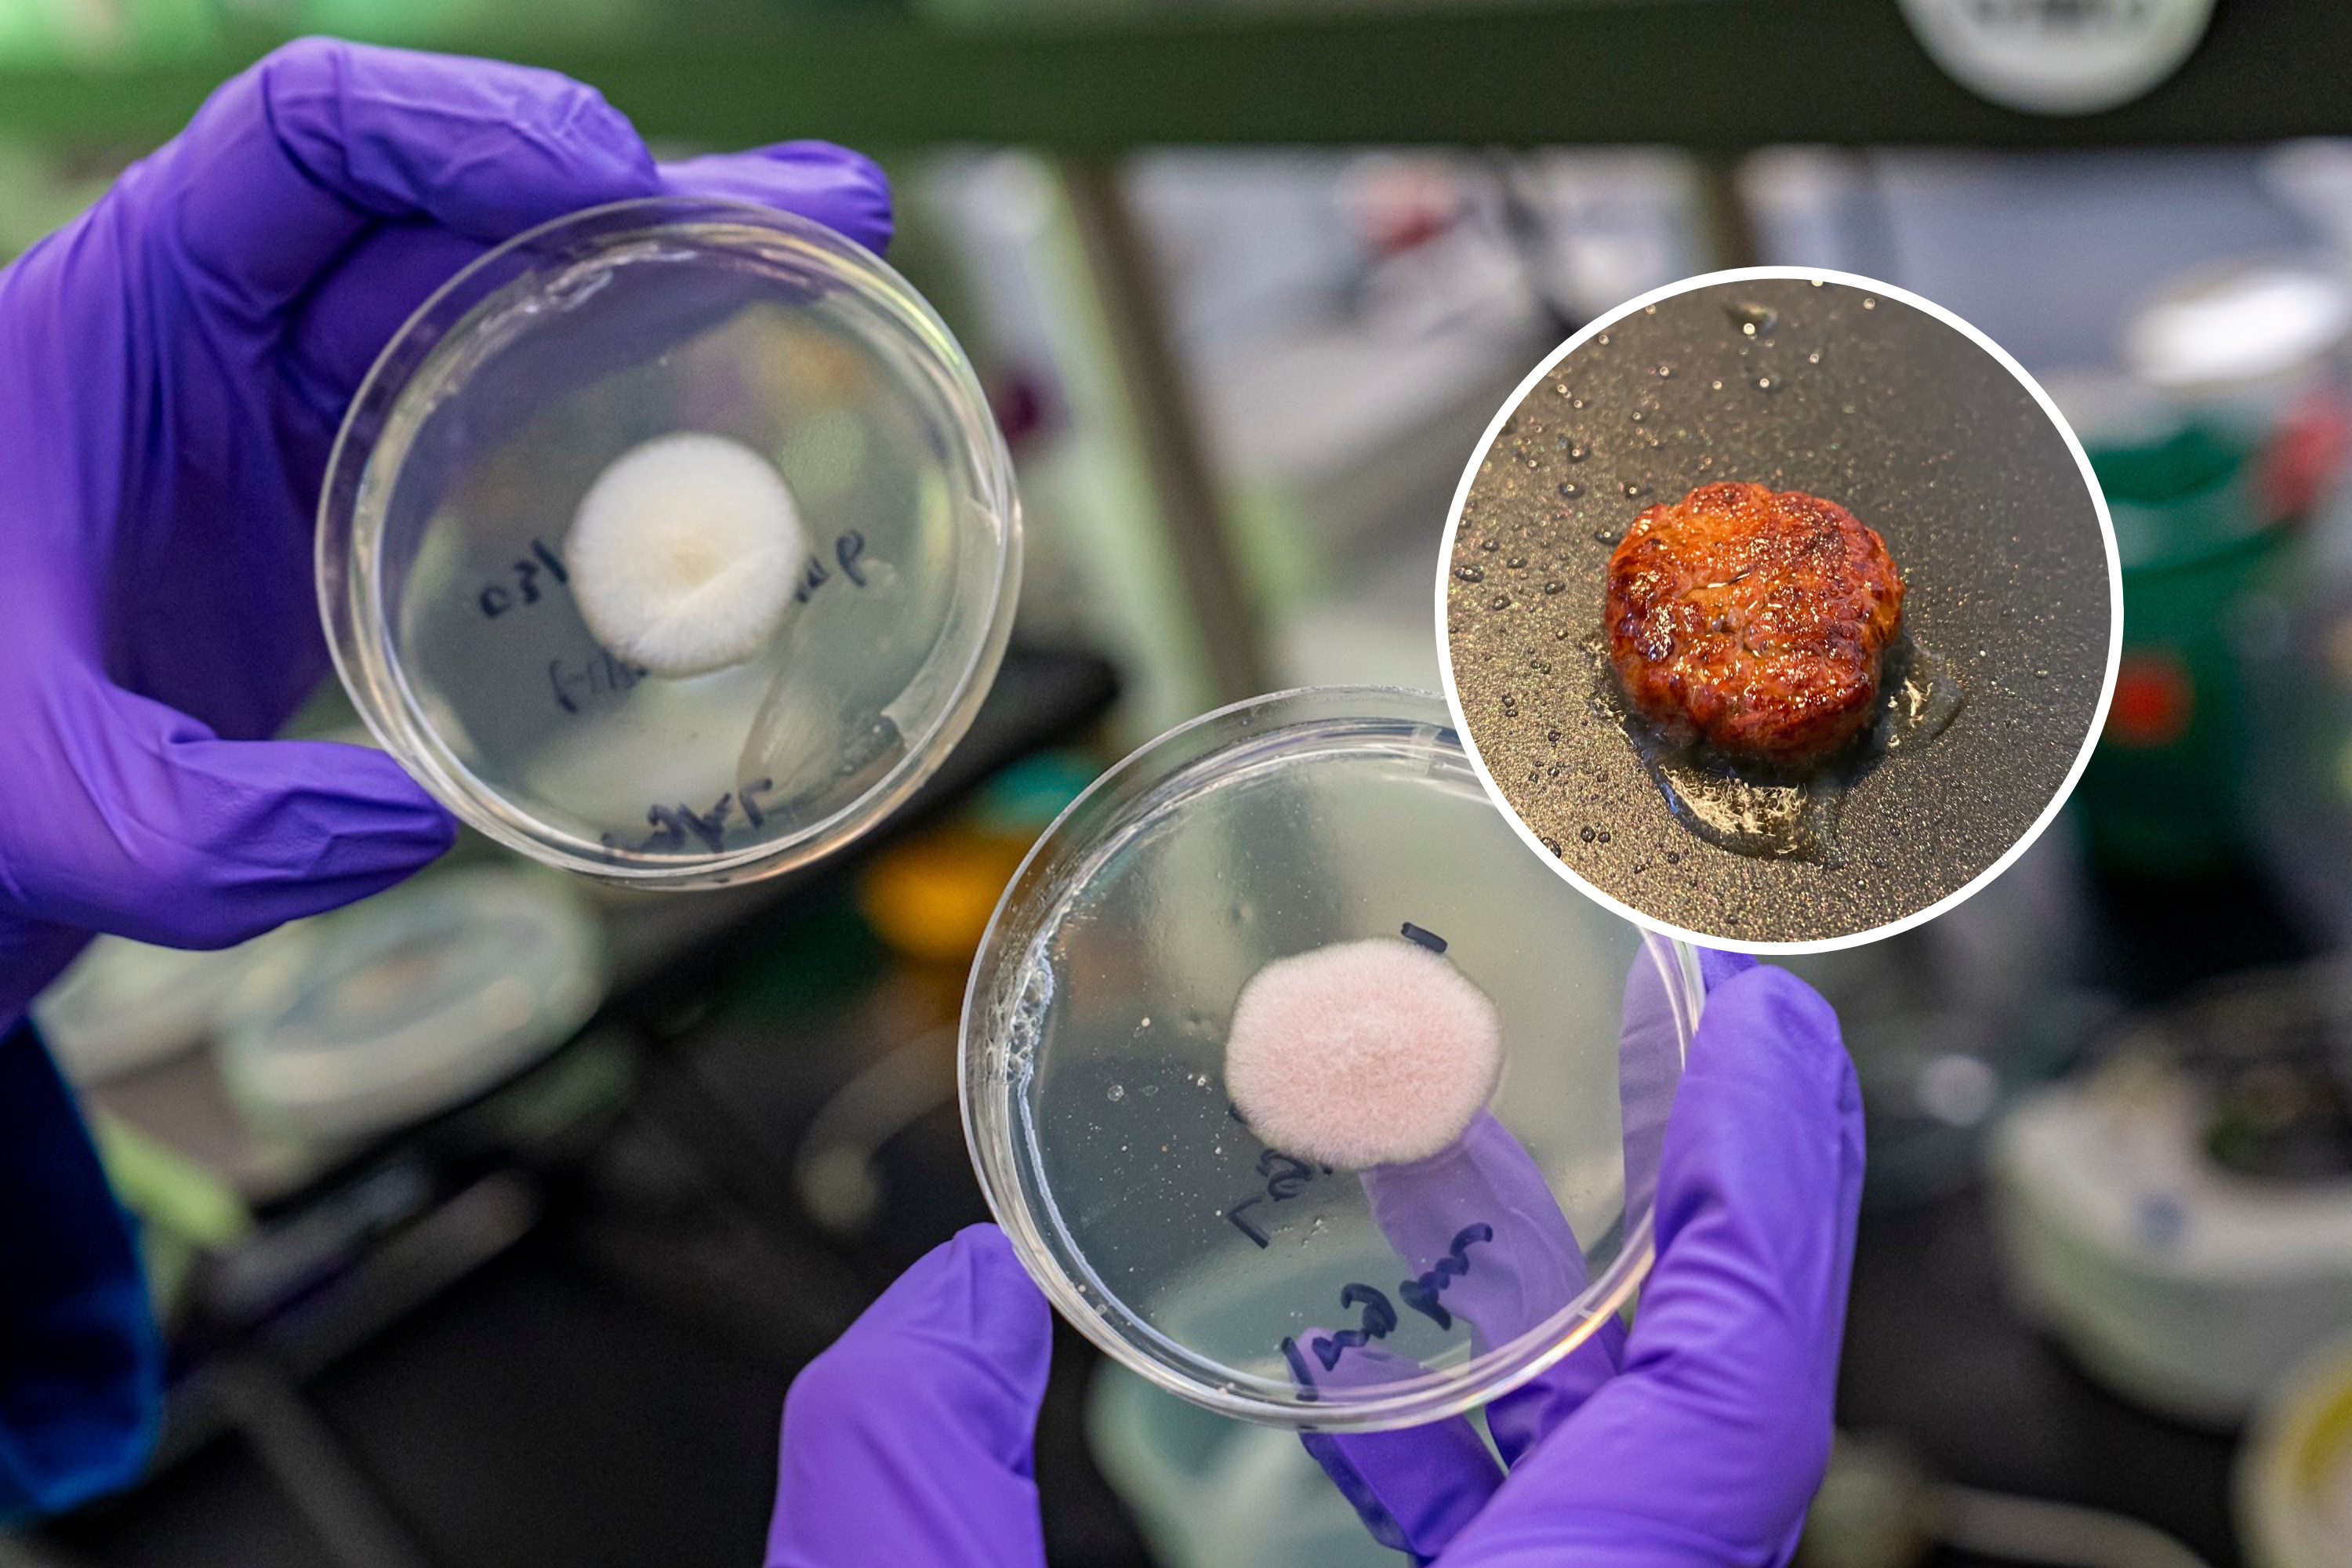
Featured image for "Lab-Grown Mold Burger: The Surprising New Meat Replacement"

Fermentation Enthusiast's Delight: Crafting Creamy Ant Yoghurt
Researchers explore the traditional and scientific aspects of making ant yoghurt, a fermented treat from Bulgaria and Turkey, revealing that ants contribute microbes and formic acid to ferment milk into yoghurt. While promising for food innovation, ethical and sustainability concerns prevent DIY attempts, but the research opens possibilities for novel flavors and plant-based alternatives.